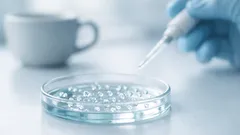
Rasvakudoksesta organoideja ilman geenimuuntelua – uusi RMF-mikrokudos voi muuttaa tutkimusta

Suositellut artikkelit

Teknologia ja kehitys
Rasvakudoksesta organoideja ilman geenimuuntelua – uusi RMF-mikrokudos voi muuttaa tutkimusta

Muoti ja sisustus
Näin teet oliivipurkista tyylikkään sisustusesineen alle 10 minuutissa

Taide, kulttuuri ja viihde
Hastrupin aarre: Jyllannin metsästä löytynyt pronssikätkö paljastaa muinaiset verkostot

Muoti ja sisustus
Näin sulatat pakastimen nopeasti: suola ja etikka irrottavat jään ilman rapsuttelua

Elämäntyyli ja ihmissuhteet
5 käytännöllistä tapaa käyttää munakennot uudelleen kotona – ja milloin ne kannattaa kierrättää

Elämäntyyli ja ihmissuhteet
Yksi virhe, joka paljasti, mitä ei koskaan pitäisi huuhdella vessanpöntöstä

Elämäntyyli ja ihmissuhteet
Muovipullon korkki on arjen pikkutyökalu: 6 siistiä keittiövinkkiä

Muoti ja sisustus
Miten yhdistellä moderneja koruja: 5 korua, jotka riittävät korurasiaasi

Ruoka ja reseptit
Näin puhdistat moka-pannun sitruunahapolla ja saat kahvin maun takaisin

Muoti ja sisustus
Uunin luukun puhdistus helposti: ruokasooda ja etikka kirkastavat lasin

Elämäntyyli ja ihmissuhteet
Poista pinttynyt rasva keittotasosta budjettiystävällisellä seoksella
Teknologia ja kehitys
Rasvakudoksesta organoideja ilman geenimuuntelua – uusi RMF-mikrokudos voi muuttaa tutkimusta

Terveys ja hyvinvointi
Ruokavalion laatu ja aivoterveys: miksi valinnat jo lapsuudessa näkyvät vielä vanhuudessa

Terveys ja hyvinvointi
Keitä appelsiinin ja sitruunan kuoret kanelin kanssa – helppo niksi kodin raikkaaseen tuoksuun

Teknologia ja kehitys
3D-tulostettava elävä rakennusmateriaali sitoo hiilidioksidia – näin se toimii

Teknologia ja kehitys
Pallomainen aurinkokenno haastaa perinteisen paneelin – mitä 3D-muoto tuo aurinkosähköön

Puutarha ja vapaa-aika
Kommentit